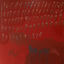

Oster- und Frühlingslieder
Deezer Kids Editor DE
Playlist • 60 Titel • 2 Std. 41 Min.

So ein schöner Tag (Fliegerlied)
Chart KidsSo ein schöner Tag (Fliegerlied)

Osterlied
DikkaOsterlied
Die Biene Maja (Vorspann Version/ Main Theme)
Karel GottDie Biene Maja (Vorspann Version/ Main Theme)

Für immer Frühling
SOFFIEFür immer Frühling

Immer wieder kommt ein neuer Frühling
Rolf Zuckowski und seine FreundeImmer wieder kommt ein neuer Frühling

Nach draußen gehn
herrHNach draußen gehn

Elektrisches Gefühl
JuliElektrisches Gefühl

Häschen hüpf
Deine FreundeHäschen hüpf

Warum bin ich so fröhlich?
Giraffenaffen, Leslie ClioWarum bin ich so fröhlich?

Guck mal diese Biene da Summ Summ
LichterkinderGuck mal diese Biene da Summ Summ

Guten Morgen Sonnenschein
Nana MouskouriGuten Morgen Sonnenschein

Ostereier-Detektive
Reinhard HornOstereier-Detektive

Alles wird grün
Johannes StankowskiAlles wird grün

April
Tim BendzkoApril

Kuckuck, Kuckuck rufts aus dem Wald
Rundfunk-Kinderchor BerlinKuckuck, Kuckuck rufts aus dem Wald

Ich bin ein kleiner Hase
Volker RosinIch bin ein kleiner Hase

Die Welt ist voller Farben (Lustiges Osterhasen-Lied für Kinder)
SternschnuppeDie Welt ist voller Farben (Lustiges Osterhasen-Lied für Kinder)

Auf unsrer Wiese gehet was
eneMeneAuf unsrer Wiese gehet was

Verstecken spielen
Die Biene MajaVerstecken spielen

Die Vogelhochzeit
Simone Sommerland, Karsten Glück, Die Kita-FröscheDie Vogelhochzeit

Vielen Dank für die Blumen
Dendemann, GiraffenaffenVielen Dank für die Blumen

Au! Auweia! Raue Frühlingsfeier! (Lustiges Frühlingslied für Kinder)
SternschnuppeAu! Auweia! Raue Frühlingsfeier! (Lustiges Frühlingslied für Kinder)
rosa rugosa
Lucry & Suena, Blumengarten, 01099, Zachi, Gustavrosa rugosa

Eier Raten Lied
Hurra KinderliederEier Raten Lied

Auf der Mauer, auf der Lauer
Marquess, GiraffenaffenAuf der Mauer, auf der Lauer

Wann kommst du Osterhase? (feat. Moritz)
Detlev JöckerWann kommst du Osterhase? (feat. Moritz)

Veronika, der Lenz ist da
Palast Orchester mit seinem Sänger Max RaabeVeronika, der Lenz ist da

Mary hat ein kleines Lamm
3BerlinMary hat ein kleines Lamm

Frohe Ostern
Simone Sommerland, Karsten Glück, Die Kita-FröscheFrohe Ostern

Dann ist der Frühling da! (Fröhliches Kinderlied zum Frühling)
SternschnuppeDann ist der Frühling da! (Fröhliches Kinderlied zum Frühling)

Wenn Du richtig glücklich bist
Nico Santos, GiraffenaffenWenn Du richtig glücklich bist

Ostereier Malwettbewerb
Familie SonntagOstereier Malwettbewerb

Sonne
Marie ReimSonne

Ich lieb den Frühling
Simone Sommerland, Karsten Glück, Die Kita-FröscheIch lieb den Frühling

Das kleine Küken piept
Giraffenaffen, JuliDas kleine Küken piept

Stups, der kleine Osterhase
Rolf Zuckowski und seine FreundeStups, der kleine Osterhase

Probiers mal mit Gemütlichkeit
Jupiter Jones, GiraffenaffenProbiers mal mit Gemütlichkeit

Hoppelhase Hans
Tikki ClubHoppelhase Hans

Es grünt so grün (My Fair Lady)
Grosses Orchester mit Chor und SolistenEs grünt so grün (My Fair Lady)

Jetzt kommt die Osterzeit
Rolf Zuckowski und seine FreundeJetzt kommt die Osterzeit